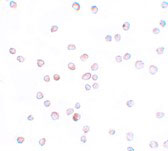
ICC - SCUBE2 Antibody ASC11166

SCUBE2 Antibody
- SPECIFICATION
- CITATIONS
- PROTOCOLS
- BACKGROUND

Application
| WB, IF, ICC, E |
|---|---|
| Primary Accession | Q9NQ36 |
| Other Accession | NP_066025, 283046663 |
| Reactivity | Human, Rat |
| Host | Rabbit |
| Clonality | Polyclonal |
| Isotype | IgG |
| Calculated MW | 109957 Da |
| Application Notes | SCUBE2 antibody can be used for detection of SCUBE2 by Western blot at 1 µg/mL. Antibody can also be used for immunocytochemistry starting at 20 µg/mL. For immunofluorescence start at 20 µg/mL. |
| Gene ID | 57758 |
|---|---|
| Target/Specificity | SCUBE2; |
| Reconstitution & Storage | SCUBE2 antibody can be stored at 4℃ for three months and -20℃, stable for up to one year. As with all antibodies care should be taken to avoid repeated freeze thaw cycles. Antibodies should not be exposed to prolonged high temperatures. |
| Precautions | SCUBE2 Antibody is for research use only and not for use in diagnostic or therapeutic procedures. |
| Name | SCUBE2 (HGNC:30425) |
|---|---|
| Synonyms | CEGP1 |
| Function | Lipid-binding protein required for SHH long-range signaling by binding to the dually lipid-modified SHH (ShhNp) and by promoting ShhNp mobilization, solubilization and release from the cell membrane (PubMed:22677548, PubMed:22902404). Acts by enhancing the proteolytic processing (shedding) of the lipid-modified N- and C- terminal of ShhNp at the cell surface (PubMed:24522195). Synergizes with DISP1 to increase SHH secretion (PubMed:22902404). Probable cell surface coreceptor for VEGFR2 involved in VEGFR2-mediated angiogenesis (PubMed:27834687). |
| Cellular Location | Secreted. Cell surface. Note=Secreted and tethered at the cell surface (PubMed:19480626). |
| Tissue Location | Expressed in a broad spectrum of adult tissues (PubMed:12270931). |

Thousands of laboratories across the world have published research that depended on the performance of antibodies from Abcepta to advance their research. Check out links to articles that cite our products in major peer-reviewed journals, organized by research category.
info@abcepta.com, and receive a free "I Love Antibodies" mug.
Provided below are standard protocols that you may find useful for product applications.
Background
SCUBE2 Antibody: SCUBE2 is a member of a family of secreted glycoproteins that contain N-terminal EGF-like repeats and C-terminal cysteine-rich motifs and CUB domain and are expressed in embryonic neuroectoderm and vascular epithelium. SCUBE2 is a close homolog to SCUBE1 and can form a heterodimeric complex with SCUBE1. SCUBE2 is thought to participate in the Hedgehog signaling pathway by specifically interacting with Sonic Hedgehog (SHH) and the receptor PTCH1, enhancing the SHH signaling activity in the raft microdomains of the plasma membrane, and may thus play important roles in organ development and tumor progression.
References
Grimmond S, Larder R, Van Hateren N, et al. Cloning, mapping, and expression analysis of a gene encoding a novel mammalian EGF-related protein (SCUBE1). Genomics2000; 70:74-81.
Yang RB, Ng CK, Wasserman SM, et al. Identification of a novel family of cell-surface proteins expressed in human vascular endothelium. J. Biol. Chem.2002; 277:46364-73.
Grimmond S, Larder R, Van Hateren N, et al. Cloning, mapping, and expression analysis of a gene encoding a novel mammalian EGF-related protein (SCUBE1). Genomics2000; 70:74-81.
Tsai M, Cheng C, Lin Y, et al. Isolation and characterization of a secreted, cell-surface glycoprotein SCUBE2 from humans. Biochem. J. 2009; 422:119-28.
If you have used an Abcepta product and would like to share how it has performed, please click on the "Submit Review" button and provide the requested information. Our staff will examine and post your review and contact you if needed.
If you have any additional inquiries please email technical services at tech@abcepta.com.













 Foundational characteristics of cancer include proliferation, angiogenesis, migration, evasion of apoptosis, and cellular immortality. Find key markers for these cellular processes and antibodies to detect them.
Foundational characteristics of cancer include proliferation, angiogenesis, migration, evasion of apoptosis, and cellular immortality. Find key markers for these cellular processes and antibodies to detect them. The SUMOplot™ Analysis Program predicts and scores sumoylation sites in your protein. SUMOylation is a post-translational modification involved in various cellular processes, such as nuclear-cytosolic transport, transcriptional regulation, apoptosis, protein stability, response to stress, and progression through the cell cycle.
The SUMOplot™ Analysis Program predicts and scores sumoylation sites in your protein. SUMOylation is a post-translational modification involved in various cellular processes, such as nuclear-cytosolic transport, transcriptional regulation, apoptosis, protein stability, response to stress, and progression through the cell cycle. The Autophagy Receptor Motif Plotter predicts and scores autophagy receptor binding sites in your protein. Identifying proteins connected to this pathway is critical to understanding the role of autophagy in physiological as well as pathological processes such as development, differentiation, neurodegenerative diseases, stress, infection, and cancer.
The Autophagy Receptor Motif Plotter predicts and scores autophagy receptor binding sites in your protein. Identifying proteins connected to this pathway is critical to understanding the role of autophagy in physiological as well as pathological processes such as development, differentiation, neurodegenerative diseases, stress, infection, and cancer.